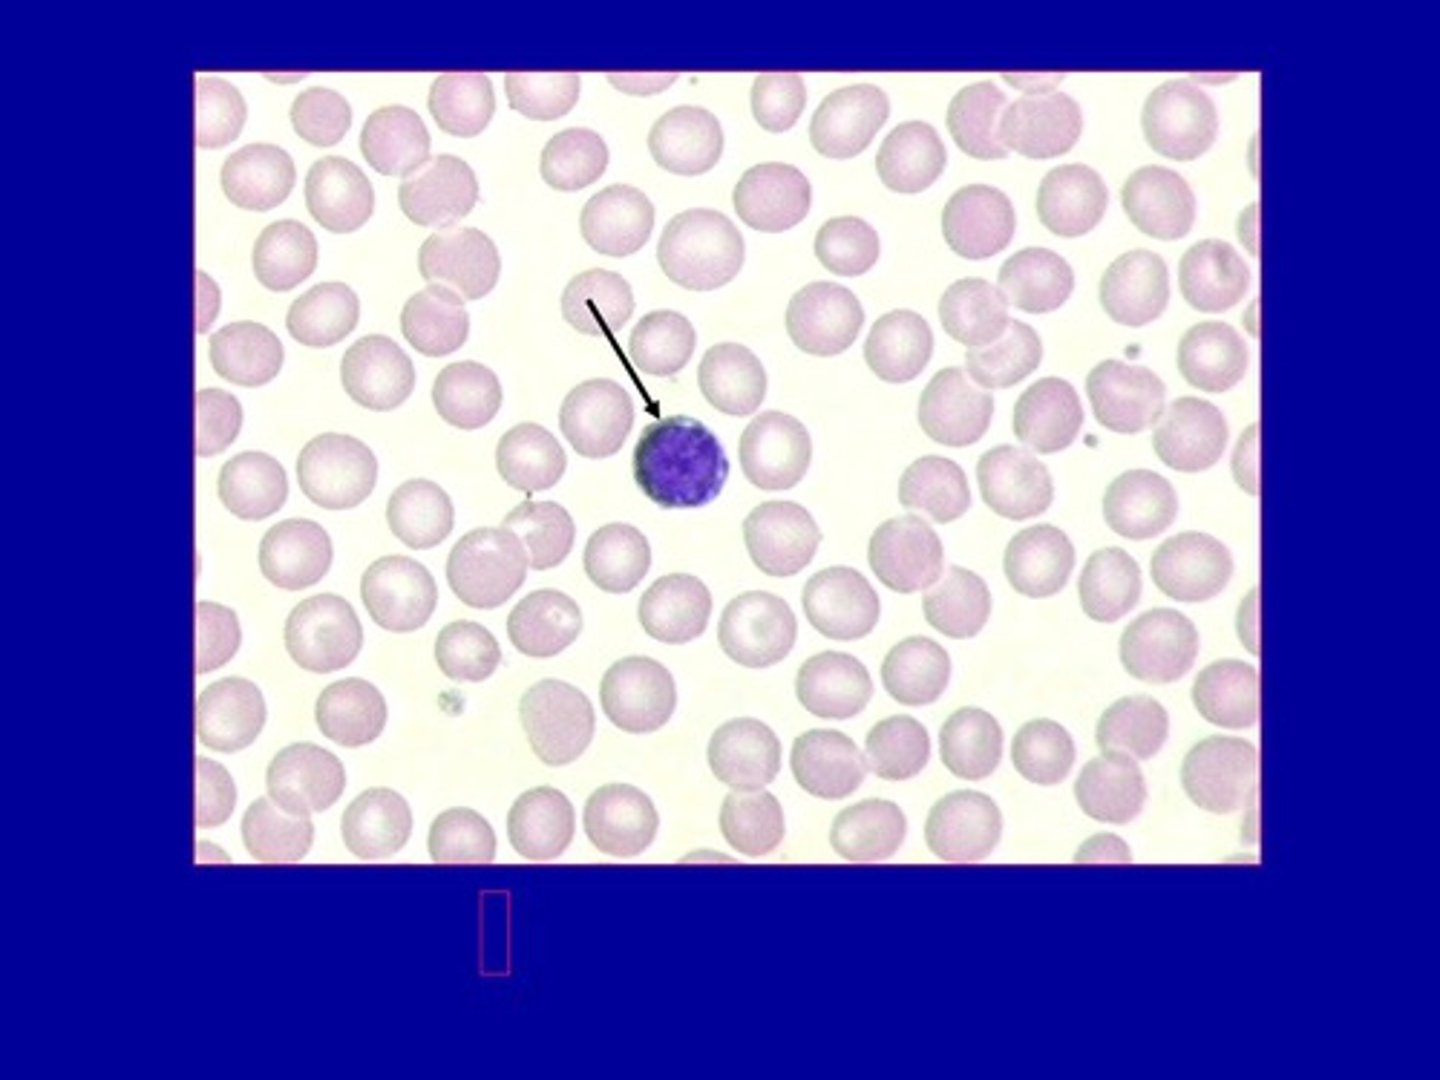
<p>white blood cells</p>
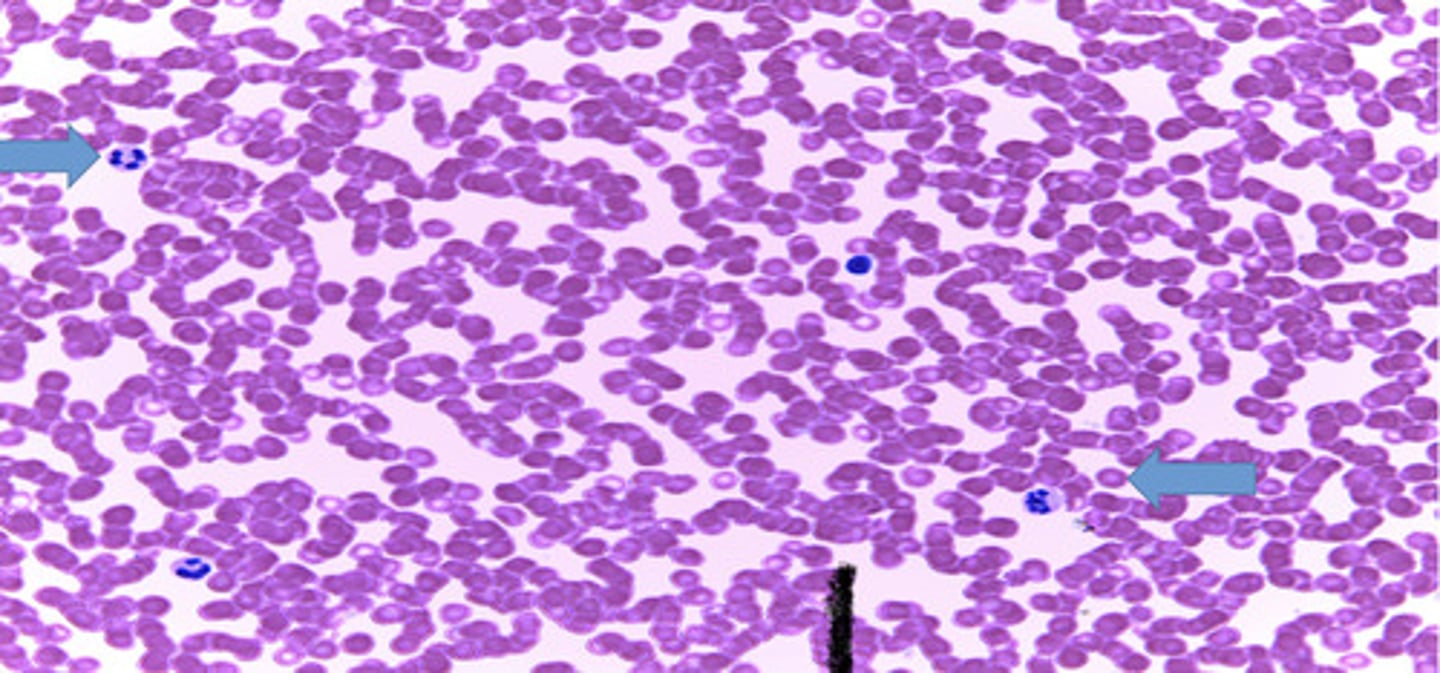
knowt flashcard image

Human Anatomy with pictures
1/119
There's no tags or description
Looks like no tags are added yet.
Name | Mastery | Learn | Test | Matching | Spaced | Call with Kai |
|---|
No analytics yet
Send a link to your students to track their progress
120 Terms
glomerulus
tiny ball of capillaries in the kidney

structure capsule (glomerular)

simple cuboidal epithelium
single layer of cube shaped cells

stratified nonkeratinized epithelium

lumen
space within a tubular part or organ, such as the space within a blood vessel

smooth muscle
involuntary muscle found in internal organs

visceral peritoneum
covers organs

simple squamous epithelium
single layer of flattened cells

lamina propria
underlying layer of areolar tissue that supports the respiratory epithelium

simple columnar epithelium
Made up of a single layer of tall cells that fit closely together

villi
Tiny finger-shaped structures that cover the inner surface of the small intestine and provide a large surface area through which digested food is absorbed

goblet cell
a column-shaped cell found in the respiratory and intestinal tracts, which secretes the main component of mucus.

brush border
Surface of a cell covered with microvilli. increases surface area of a cell for absorption

nucleus of simple columnar epithelial cell (#3)

mucus
A thick, slippery substance produced by the body

unicellular mucous glands
goblet cells

colloid
a mixture consisting of tiny particles that are intermediate in size between those in solutions and those in suspensions and that are suspended in a liquid, solid, or gas

alvelous
air sac in the lung

hyaline cartilage
Translucent bluish white cartilage consisting of cells embedded in an apparently homogeneous matrix, present in joints and respiratory passages, and forming most of the fetal skeleton

pseudostratified ciliated columnar epithelium
lines the respiratory tract

simple squamous epithelium

cardiac muscle
Involuntary muscle tissue found only in the heart.

striated muscle
A muscle that appears banded.

skeletal muscle
A muscle that is attached to the bones of the skeleton and provides the force that moves the bones.

compact bone
dense, hard layers of bone tissue that lie underneath the periosteum

osteon
functional unit of compact bone

Canaliculi
little channels that connect lacunae

Haversian canal
Channels in bone that contain blood vessels and nerves

Osteocytes
mature bone cells

Lamellae
rings around the central canal, sites of lacunae

glandular epithelium
Composed of cells specialized to produce and secrete substances into ducts or into body fluids

adipose tissue
Tissue that stores fat.

lacuna
an empty space or missing portion

a collection of 4 cells in the same lacuna is called?
locule
Basal surface (basement membrane)
surface attached to underlying tissue; provide nutrient exchange.

apical surface
an upper free surface exposed to the body exterior or the cavity of an internal organ

chondrocyte
a cell that has secreted the matrix of cartilage and become embedded in it.

elastic cartilage
external ear, epiglottis

elastic fibers
Flexible and "stretchy" fibers that add elasticity to tissue

Nucleate erythrocytes
Leucocytes
white blood cells
Which organ is this?
Kidney

Which organ is this?
Esophagus

Which organ is this?
Small intestine

Which organ is this?
Thyroid gland

Which organ is this?
Lung

What is this a picture of?
trachea

blood cells
muscular system
enables movement of the body and internal organs

nervous system
brain, spinal cord, nerves

endocrine system
Consists of glands that control many of the body's activities by producing hormones.

cardiovascular system
heart and blood vessels

lymphatic system
Composed of a network of vessels, ducts, nodes, and organs. Provides defense against infection.

respiratory system
Brings oxygen into the body. Gets rid of carbon dioxide.

proximal
Closer to the point of attachment

distal
away from the point of attachment

lateral
away from the midline of the body; to the side

inferior
below

superior
above

Dorsal
back

anterior
front

ventral
front

Posterior
back

caudal
tail
umbilical region
The centermost region, which includes the umbilicus

epigastric region
superior to the umbilical region

hypogastric region
inferior to the umbilical region

Mediastinum
space between the lungs

Diaphragm
Large, flat muscle at the bottom of the chest cavity that helps with breathing

Abdominal pelvic cavity
Inferior subdivision below diaphragm

thoracic cavity
contains heart and lungs

pelvic cavity
Contains urinary bladder, reproductive organs, and rectum

pleural cavity
lungs

pericardial cavity
heart

superficial
near the surface

deep
away from the surface
ipsilateral
on the same side of the body
Contraleteral
on the opposite side of the body
gland duct (1)
ID structure

transitional epithelium
function: stretches readily and permits distension of urinary organ by contained urine
Location: lines the ureters, urinary bladder, and part of the urethra

ground substance
unstructured material that fills the space between the cells and contains the fibers

collagen fiber
flexible fibrous proteins that give connective tissue tensile strength

adipocyte
fat cell

reticular tissue
Forms internal supporting framework of soft organs such as the spleen

reticular fiber
fine fibrous protein, made of collagen subunits, which cross-link to form supporting "nets" within connective tissue

dense regular tissue
tendons and ligaments

dense irregular tissue
irregularty arranged collaged fibers with few fibroblasts, withstands pulling in many directions

dense elastic connective tissue
dense regular connective tissue containing a high proportion of elastic fibers

spongy bone
Layer of bone tissue having many small spaces and found just inside the layer of compact bone.

compact bone
Hard, dense bone tissue that is beneath the outer membrane of a bone

osteoblasts
bone forming cells

bone marrow
A soft tissue inside the bone that produces blood cells

Erythrocytes
red blood cells

Fibrocartilage
cartilage that contains fibrous bundles of collagen, such as that of the intervertebral disks in the spinal cord.

skeletal muscle fiber
a single cell that contracts in response to stimulation and then relaxes when the stimulation ends

dendrites
receive messages from other cells

cell body
the cell's life support center

axon
A threadlike extension of a neuron that carries nerve impulses away from the cell body.

nervous tissue
neurons and neuroglia

stratum corneum
outermost layer of epidermis
